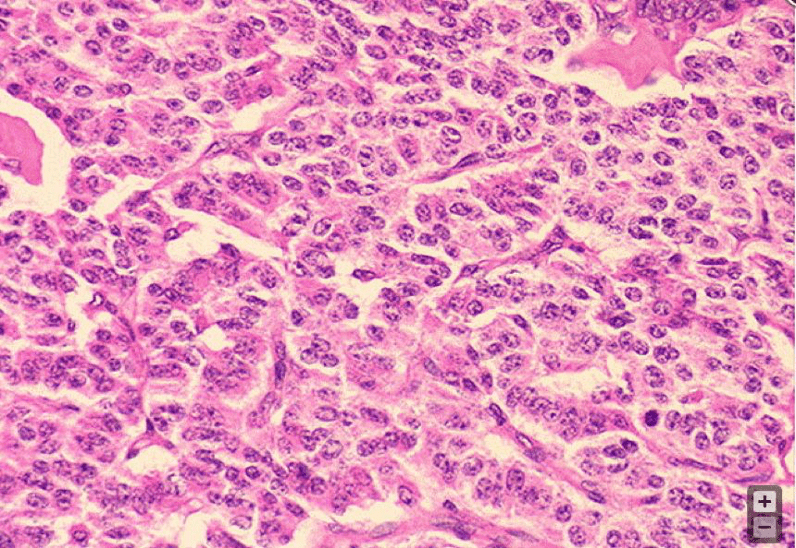

This tripeptide in blood cardioplegia scavenges oxygen-free radicals
What is glutathione?
Percentage of thoracic outlet syndrome that are neurogenic
What is 90%
The vessel most likely to be injured during placement of the anterior commissure suture during mitral valve annuloplasty
What is the left circumflex artery?
Diagnosis when high-resolution manometry shows impaired LES relaxation and absent peristalsis
What is achalasia?
Loss of nuclear expression of this gene is highly specific for pleural mesothelioma

What is BAP1 (BRCA1-associated protein 1)?

Type of cardioplegia that provides uniform distribution to the subendocardium but is contraindicated in patients with significant aortic insufficiency
What is antegrade cardioplegia?
Physical exam maneuver to test for thoracic outlet syndrome where patient slowly opens and closes their hands for 3 min the below position.

What is the Elevated Arm Stress Test (EAST, aka Roos test)?


The base of this leaflet, which corresponds to the intertrigonal distance, is used as a reference for sizing tricuspid annuloplasty rings
What is the septal leaflet?

Direction of gastric volvulus

What is mesenteroaxial?
The implanted medical device below


What is a mitra leadless cardiac pacemaker?
A complication that can result from excessive volume or pressure during retrograde cardioplegia
What is coronary sinus rupture?
Most common primary malignant chest wall tumor
What is chondrosarcoma?
Tricuspid valve repair is reasonable for patients with progressive (Stage B) tricuspid regurgitation undergoing mitral valve surgery when tricuspid annular end-diastolic diameter is greater than this threshold
What is 4.0 cm?
The vertebral level where the azygos vein travels over the right main bronchus
What is T4?
Positive p40, negative TTF-1
What is squamous cell carcinoma?
This anatomical structure may limit uniform cardioplegia distribution in retrograde delivery, especially to the right ventricle
What is the Thebesian venous system?
Two chest wall tumor histologies where surgery is warranted for diagnosis only
What are plasmacytoma and lymphoma?
A degenerative mitral valve disease in which myxoid infiltration of the valve results in a myxomatous-appearing valve where the hallmark is excess thickened leaflet tissue
What is Barlow’s disease?

Complication after Nissen fundoplication with this postop barium swallow and EGD view looking at the hiatus


What is a slipped wrap?
Diagnosis for pathology below (salt and pepper chromatin with 3 mitoses per 2 mm²)

What is atypical carcinoid?
Atypical carcinoids have 2-10 mitoses per 2 mm² or the presence of necrosis.
Typical carcinoids have <2 mitoses per 2mm².
For each 1°C drop in temperature, myocardial oxygen demand decreases by this percentage
What is 5-7%?
Size of anterior chest wall defect during chest wall tumor resection that should get a rigid or semirigid prosthesis
What is 5cm or greater?
The study that standard selection criteria for TEER for secondary MR are based off of, per the ACC/AHA 2020 Guidelines
What is the COAPT trial?
The enrollment criteria in COAPT trial were LVEF 20-50%, LVESD ≤70 mm, PASP ≤70 mmHg, and persistent symptoms [NYHA class II, III, or IV] while on optimal GDMT (guideline-directed medical therapy
Autosomal recessive congenital disorder classically characterized by a triad of ACTH-resistant adrenal insufficiency, alacrimia, and achalasia
What is Allgrove syndrome?
Name the coronary cusp indicated by the arrow
What is the right coronary cusp?